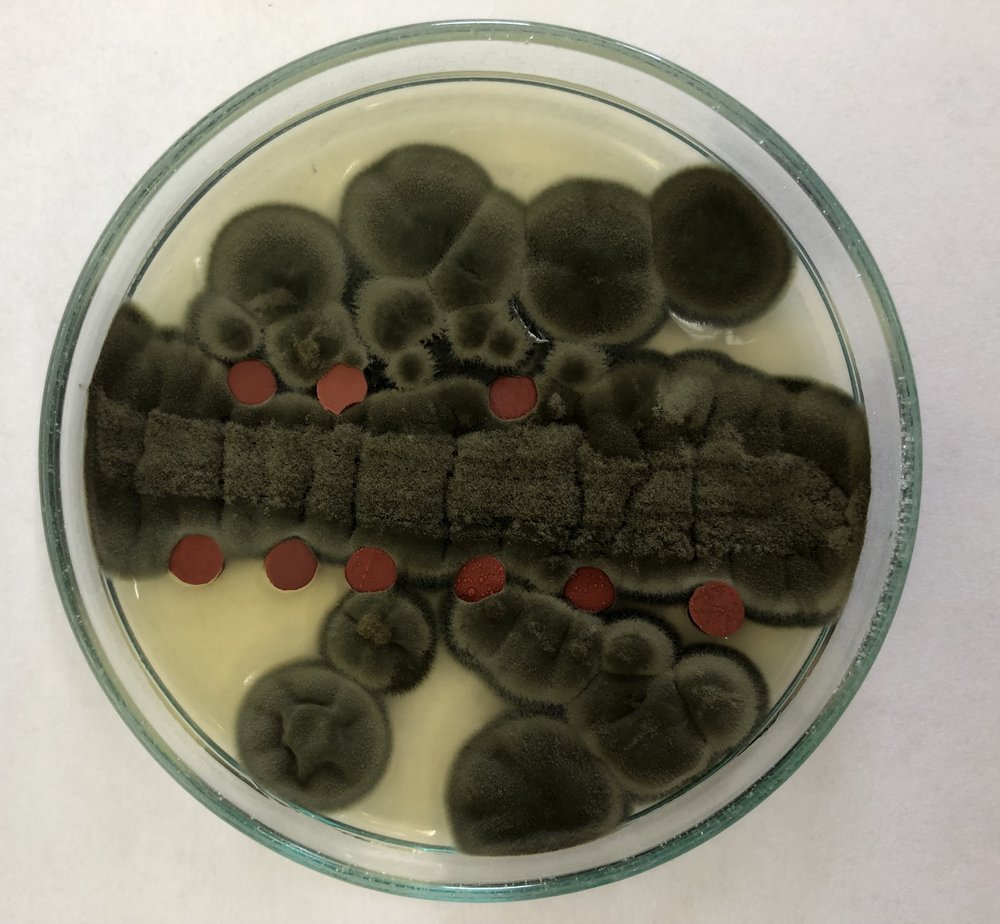
zdjęcie z prac laboratoryjnych

Współpraca WBiOŚ z UNIRUBBER sp. z o.o.
UNIRUBBER sp. z o.o. jest liderem w branży producentów nawierzchni użytkowych do zastosowań zewnętrznych oraz wewnętrznych. Działa na rynku od ponad 30 lat. Granulaty gumowe wytwarzane w przedsiębiorstwie są rozpowszechnione na całym świecie, a z bezpośredniej produkcji trafiają do 23 państw europejskich, Stanów Zjednoczonych i ściany wschodniej. Współpraca UNIRUBBER z firmami ‘siostrami’, które zajmują się wytwarzaniem komponentów wchodzących w skład sztucznej nawierzchni sportowej, w ramach holdingu, daje możliwość znacznego zwiększenia zasięgu organizacji i kompleksowego spełnienia oczekiwańnia klientów. Jako firma należąca do czołówki światowych leaderów w ciągły sposób udoskonala przestrzenie sportowe i rekreacyjne, korzystając zaawansowanej i ciągle rozwijanej infrastruktury laboratoryjnej, zmniejsza w swoich produktach wpływ na środowisko. Oferta firmy obejmuje przede wszystkim granulaty z produkcji pierwotnej, tzw. „virgin” oraz granulaty z recyklingu gumowych odpadów technicznych. Angażuje najlepszych specjalistów i technologie, aby sprostać wymaganiom klientów oraz partnerów biznesowych.
Tym razem poprzez współpracę ze specjalistkami z UŁ, dr hab. Sylwią Różalską, prof. UŁ oraz dr Aleksandrą Budzyńska oraz studentką i studentem kierunku Biotechnologia Wydziału BiOŚ, Katarzyną Prochoń i Mikołajem Cybulskim, przedsiębiorstwo zleciło przeprowadzenie badań swoich produktów, w zakresie właściwości przeciwdrobnoustrojowych - hamowania rozwoju bakterii i grzybów niekorzystnie wpływających na zdrowie użytkowników obiektów sportowych i rekreacyjnych, w tym placów zabaw, gdzie najistotniejsze jest bezpieczeństwo i zdrowie najmłodszych.
Współpraca z badaczkami Wydziału BiOŚ układa się bardzo owocnie i jest przykładem na znalezienie wspólnego języka przedsiębiorców i naukowców, z korzyścią dla bezpieczeństwa odbiorców końcowych - nas wszystkich -
dodaje Pan Marcin Marczak – Dyrektor ds. Technicznych i Rozwoju firmy UNIRUBBER.
Przebieg projektu i wyniki badań
Po przedyskutowaniu wyników badań z dyrektorem ds. technicznych i rozwoju UNIRUBBER sp. z o.o., Panem Marcinem Marczakiem zadecydowano o kontynuacji współpracy w dodatkowym zadaniu badawczym prowadzonym z udziałem Fundacji Uniwersytetu Łódzkiego. Badania zostaną zakończone w październiku br. Ich owocem są nie tylko wyniki badań, które bezpośrednio wpłyną na bezpieczeństwo społeczne i odpowiedzą na potrzebę firmy, ale również staż naukowy, który Pan Marcin Marczak odbył w Instytucie Mikrobiologii, Biotechnologii i Immunologii UŁ. W opracowaniu jest wspólna publikacja, a badania będą kontynuowane w ramach dalszej współpracy, po której, jak deklaruje przedstawiciel przedsiębiorstwa – Pan Marcin Marczak „Przedsiębiorstwo planuje komercjalizację materiału o potwierdzonych właściwościach przeciwdrobnoustrojowych”.
Kontynuacja współpracy
Po przedyskutowaniu wyników badań z dyrektorem ds. technicznych i rozwoju UNIRUBBER sp. z o.o., Panem Marcinem Marczakiem zadecydowano o kontynuacji współpracy w dodatkowym zadaniu badawczym prowadzonym z udziałem Fundacji Uniwersytetu Łódzkiego. Badania zostaną zakończone w październiku br. Ich owocem są nie tylko wyniki badań, które bezpośrednio wpłyną na bezpieczeństwo społeczne i odpowiedzą na potrzebę firmy, ale również staż naukowy, który Pan Marcin Marczak odbył w Instytucie Mikrobiologii, Biotechnologii i Immunologii UŁ. W opracowaniu jest wspólna publikacja, a badania będą kontynuowane w ramach dalszej współpracy, po której, jak deklaruje przedstawiciel przedsiębiorstwa – Pan Marcin Marczak „Przedsiębiorstwo planuje komercjalizację materiału o potwierdzonych właściwościach przeciwdrobnoustrojowych”.
Informacje o projektach
Projekty realizowane zostały w ramach Science Hub UŁ – ogólnouczelnianej platformy współpracy, która ma na celu wspieranie społeczności akademickiej UŁ w realizacji wdrożeniowych projektów naukowych we współpracy z otoczeniem.
Tytuł projektu: Ocena przeciwbakteryjnych właściwości ekologicznych nawierzchni rekreacyjno-sportowych
Osoba pełniąca opiekę: dr Aleksandra Budzyńska, Laboratorium Usług Mikrobiologiczno-Technicznych
Osoba studiująca: Mikołaj Cybulski, Biotechnologia medyczna
Partner: UNIRUBBER sp. z o.o.
Projekt: UNIRUBBER sp. z o.o. w ciągły sposób udoskonala przestrzenie sportowe i rekreacyjne, zmniejsza w swoich produktach wpływ na środowisko. Angażuje najlepszych specjalistów i technologie, aby sprostać oczekiwaniom klientów oraz partnerów biznesowych. Tym razem poprzez współpracę ze specjalistką z UŁ, przedsiębiorstwo zamierza zlecić przeprowadzenie badań swoich produktów, w zakresie ich właściwości przeciwdrobnoustrojowych - hamowania rozwoju bakterii chorobotwórczych. Celem projektu jest wyjście naprzeciw opisanym problemom i zbadanie działania przeciwbakteryjnego posadzek przeznaczonych do celów sportowych i rekreacyjnych.
Tytuł projektu: Przeciwgrzybicze właściwości ekologicznych nawierzchni rekreacyjno-sportowych - ochrona przed zagrożeniami zakaźnymi i środowiskowymi
Osoba pełniąca opiekę: dr hab. Sylwia Różalska, prof. UŁ, Katedra Mikrobiologii Przemysłowej i Biotechnologii
Osoba studiująca: Katarzyna Prochoń
Partner: UNIRUBBER Sp. z o.o.
Projekt: UNIRUBBER sp. z o.o. w ciągły sposób udoskonala przestrzenie sportowe i rekreacyjne, zmniejsza w swoich produktach wpływ na środowisko. Angażuje najlepszych specjalistów i technologie, aby sprostać oczekiwaniom klientów oraz partnerów biznesowych. Poprzez współpracę ze specjalistkami z UŁ, przedsiębiorstwo zamierza zlecić przeprowadzenie badań swoich produktów właściwości przeciwdrobnoustrojowych w zakresie hamowania rozwoju grzybów (w szczególności strzępkowych grzybów alergennych i toksynotwórczych oraz chorobotwórczych drożdżaków).
Tekst i zdjęcia: członkowie i członkinie zespołów projektowych
Redakcja: Science Hub UŁ